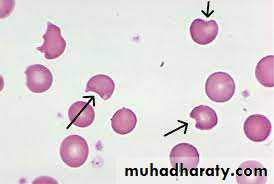

G6pd dEficiency
Also called FAVISMG6PD is an enzyme of hexose monophosphate shunt .
It is needed for the synthesis of REDUCED GLUTATHION which protects RBCs membrane and Hb against oxidative damage .
It is X-linked recessive affected mainly males , but can occur in females .
The hemolysis is intravascular .
The RBCs become liable to destruction by O2 radicles .
The defect is either functional ( the enzyme is not functioning ) or quantitative( the quantity of enzyme is not enough ) .
Precipitatng factors for hemolysis :
Usually the patient is normal and there is no hemolysis except in :1- Ingestion of favabeans ( usually fresh ) , leads to liberation of O2 radicles leading to RBCs damage .
2- infections : It leads to increased activity of neutrophils which will try to combat the infection by liberation of O2 radicles causing RBCs damage .
3- Drugs :
** Antimalarial : primaquine , chloroquine .** Analgesics : Aspirin , phenacetin
** Antibiotics : Sulphonamides , nitrofurantoin , ciprofloxacin
** Miscellaneous : quinidine , vitamin K , dapsone
4- Surgery and stressful conditions .
Clinical features :
The patient is normal but when exposed to the any of the above precipitating factors , there will be sudden and rapidly developing anemia , jaundice , fever and dark urine due to hemoglobinuria .
Investigations :
1- Anemia .2- Reticulocytosis .
3- Increased indirect bilirubin .
4- Increased LDH .
5- Blood film : ** Heinz bodies
** bite cells
6- Enzyme assays ( definitive diagnosis ) .
In patients with active hemolysis , the enzyme assay will be normal because there are some RBCs are enzyme deficient and other RBCs are normal , so when hemolysis occurs the only abnormal RBCs are destroyed and the normal will stay , so when we do the enzyme assays we will find normal enzyme assay , so we should wait for one month at least after active hemolysis and then do the test .Also following blood transfusion , the test will be normal .
1- Avoid precipitating factors .
2- For acute attacks :Rest
Withdrawal of the drugs
Blood transfusion for symptomatic anemia
folic acid
Any infection should be treated
The condition will resolve in 10 – 14 days .